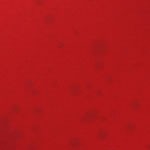

Sponsored



Vickerman Matte Mercury Ball Ornament
New at target
$41.99 reg $42.99
Sale
save $1.00 (2% off)In Stock
Eligible for registries and wish lists
Sponsored
About this item
Highlights
- Made of Shatterproof Plastic
- Drilled and wired secure cap
- Metal Cap for easy hanging
- 6 ornaments per bag
Description
Vickerman Matte Mercury Ball Ornament. This item features a matte mercury finish to add texture to any holiday decorating project as well as a metal cap for reliable hanging.
Number of Pieces: 6
Piece 1: 4.0 inches (W) x 4.0 inches (H) x 4.0 inches (D), Quantity 6
Indoor/Outdoor: Indoor
Material: Plastic
Battery: No Battery Used
TCIN: 1006630802
UPC: 734205478806
Origin: imported
The above item details were provided by the Target Plus™ Partner. Target does not represent or warrant that this information is accurate or complete. On occasion, manufacturers may modify their items and update their labels.
We recommend that you do not rely solely on the information presented. If you have a specific question about this item, you may consult the item's label, contact the manufacturer directly or call Target Guest Services at 1-800-591-3869.
If the item details aren’t accurate or complete, we want to know about it.
Shipping details
Estimated ship dimensions: 17 inches length x 5 inches width x 9 inches height
Estimated ship weight: 1 pounds
This item cannot be shipped to the following locations: American Samoa (see also separate entry under AS), Guam (see also separate entry under GU), Northern Mariana Islands, Puerto Rico (see also separate entry under PR), United States Minor Outlying Islands, Virgin Islands, U.S., APO/FPO, Alaska, Hawaii
item ships from third party seller: Vickerman
Return details
This item can be returned to any Target store or Target.com.
This item must be returned within 30 days of the date it was purchased in store, shipped, delivered by a Shipt shopper, or made ready for pickup.
See the return policy for complete information.
Guests also viewed

$36.99 - $129.99
reg $37.99 - $159.99 Sale
5 out of 5 stars with 6 ratings

$31.98 - $129.99
reg $31.99 - $159.99 Sale
4.4 out of 5 stars with 7 ratings

$24.99 - $129.99
reg $29.99 - $159.99 Sale
4.8 out of 5 stars with 17 ratings
Discover more options

$46.99 - $67.99
reg $47.99 - $72.99 Sale
5 out of 5 stars with 1 ratings

$43.99 - $56.99
reg $44.99 - $58.99 Sale
5 out of 5 stars with 4 ratings

$37.59 - $62.99
reg $43.99 - $66.99 Sale
5 out of 5 stars with 21 ratings

$29.39 - $64.99
reg $34.99 - $93.99 Sale
4.8 out of 5 stars with 11 ratings

$18.99 - $34.99
reg $23.99 - $38.99 Sale
4.7 out of 5 stars with 7 ratings
Related Categories
5.0 out of 5 stars with 3 reviews